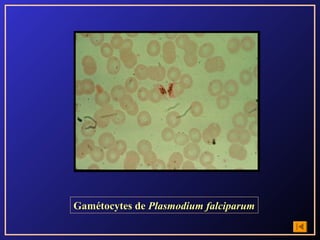
Gamétocytes de Plasmodium falciparum

Le document présente une liste variée de protistes et de helminthes, ainsi que leurs étapes de cycle évolutif et morphologie. Il mentionne des organismes tels qu'Entamoeba histolytica, Plasmodium falciparum, et Ascaris lumbricoides. Ce contenu semble axé sur la parasitologie et les différentes formes de ces parasites.